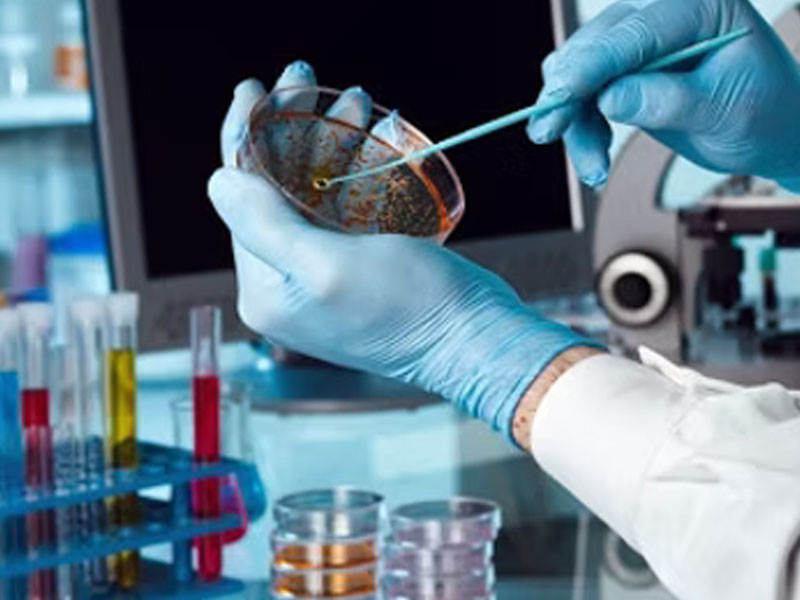

Welcome to The Neethi BioLab
Computerised Medical Laboratory
Why choose the Neethi Biolab Manna,
Accurate and Reliable Results
We use state-of-the-art technology and equipment to ensure precision and reliability in every test.
All results are verified by experienced medical professionals
Comprehensive Testing Services
From routine blood work to advanced diagnostic tests, we offer a wide range of services to meet all your healthcare needs.
Experienced Professionals
Our team includes skilled technicians with years of expertise in diagnostics.
About Us
The Neethi Biolab Manna was established in 2022 with a vision of creating awareness of a healthy lifestyle and early detection of preventable diseases through routine health screening programs.
With our convenient location, friendly assistance, professional technicians, state-of-the-art infrastructure, accurate same-day reports, and much more, we are not just a unique diagnostic center, but your trusted friend when it comes to healthcare.
Our unwavering commitment to excellence in healthcare enables us to provide affordable healthcare services and special blood tests that are conducted in our laboratory without compromising on quality and accuracy. We also offer full body health checkup packages to ensure the good health of your family at all times, making us the preferred diagnostic center for thousands of happy and healthy families, Your samples will be analyzed in ISO 1400:2015 accredited lab in shortest Turnaround time following the best clinical lab practice
Health Packages
Normal 829
Package 499/-
- Blood Glucose (Fasting Blood Sugar): (പ്രമേഹവും പ്രീ ഡയബറ്റിസും കണ്ടെത്തുന്നു)(1)
- Blood Glucose (Postprandial Blood Sugar): (ഭക്ഷണത്തിന് ശേഷം രക്തത്തിലെ പഞ്ചസാര അളക്കുക.)(1)
- HbA1c: (കഴിഞ്ഞ 2-3 മാസത്തെ രക്തത്തിലെ ശരാശരി പഞ്ചസാരയുടെ അളവ് അളക്കുന്നു)(1)
- Serum Creatinine (കിഡ്നി സംബന്ധമായ )
- Microalbumin
- Urine Albumin
- Urine Sugar
Normal rate 1499
Package rate 800/-
- Complete Blood Count- (CBC)വിളർച്ച, അണുബാധ, രോഗപ്രതിരോധ ശേഷി നില എന്നിവ വിലയിരുത്തുന്നു(20)
- Erythrocyte Sedimentation Rate (ESR) ശരീരത്തിലെ നീരു, വീക്കം കണ്ടെത്തുന്നു.(1)
- Blood Glucose (Fasting Blood Sugar): (പ്രമേഹവും പ്രീ ഡയബറ്റിസും കണ്ടെത്തുന്നു)(1)
- Lipid Profile (ഹൃദയ അപകടസാധ്യത വിലയിരുത്തുക)(7)
- Liver Function Tests (LFT): (കരളിന്റെ ആരോഗ്യവും പ്രവർത്തനവും വിലയിരുത്തുക.)(10)
- Kidney Function Tests&eGFR (KFT): വൃക്കകളുടെ ആരോഗ്യവും ,വൃക്ക തകരാറുകൾ കണ്ടെത്തുകയും ചെയ്യുക(3)
- Thyroid Function Test (TSH): തൈറോയ്ഡ് തകരാറുകൾ നിർണ്ണയിക്കുക.(1)
- Urine Routine Examination (മൂത്ര സംബന്ധമായ പരിശോധന)(14)
- Blood Pressure: (രക്തസമ്മർദ്ധം)(1)
Normal rate 1999
Package rate 1499/-
- Complete Blood Count (CBC) (വിളർച്ച, അണുബാധ, രോഗപ്രതിരോധ ശേഷി നില എന്നിവ വിലയിരുത്തുന്നു(20)
- Erythrocyte Sedimentation Rate (ESR) ശരീരത്തിലെ നീരു, വീക്കം കണ്ടെത്തുന്നു.(1)
- Blood Glucose (Fasting Blood Sugar): (പ്രമേഹവും പ്രീ ഡയബറ്റിസും കണ്ടെത്തുന്നു)(1)
- SGPT, SGOT: (കരളിന്റെ ആരോഗ്യവും പ്രവർത്തനവും വിലയിരുത്തുക.)(2)
- Serum Creatinine&eGFR: വൃക്കകളുടെ ആരോഗ്യവും ,വൃക്ക തകരാറുകൾ കണ്ടെത്തുകയും ചെയ്യുക (1)
- Lipid Profile (ഹൃദയ അപകടസാധ്യതയും ലിപിഡ് മെറ്റബോളിസവും വിലയിരുത്തുക)(7)
- TSH തൈറോയ്ഡ് തകരാറുകൾ നിർണ്ണയിക്കുക)(1)
- Calcium: (ഓസ്റ്റിയോപൊറോസിസ് പോലുള്ള അസ്ഥികളെ ബാധിക്കുന്ന അവസ്ഥകൾ വിലയിരുത്തുക)(1)
- Vitamin D3: (അസ്ഥികളെയും പ്രതിരോധശേഷിയെയും ബാധിക്കുന്ന കുറവ് കണ്ടെത്തുന്നു.)(1)
- Urine Routine Examination (മൂത്ര സംബന്ധമായ പരിശോധന)(12)
- Blood Pressur: (രക്തസമ്മർദ്ധം)(1)
ProHealth Complete Package -
Normal rate 3199 package rate 2299/-
- Complete Blood Count (CBC)( വിളർച്ച, അണുബാധ, രോഗപ്രതിരോധ ശേഷി നില എന്നിവ വിലയിരുത്തുന്നു(20)
- Erythrocyte Sedimentation Rate (ESR) ശരീരത്തിലെ നീരു, വീക്കം കണ്ടെത്തുന്നു.(1)
- Blood Glucose (Fasting Blood Sugar): (പ്രമേഹവും പ്രീ ഡയബറ്റിസും കണ്ടെത്തുന്നു)(1)
- Blood Glucose (Postprandial Blood Sugar): (ഭക്ഷണത്തിന് ശേഷം രക്തത്തിലെ പഞ്ചസാര അളക്കുക.)(1)
- HbA1c : (കഴിഞ്ഞ 2-3 മാസത്തെ രക്തത്തിലെ ശരാശരി പഞ്ചസാരയുടെ അളവ് അളക്കുന്നു)(1)
- Liver Function Tests (LFT): (കരളിന്റെ ആരോഗ്യവും പ്രവർത്തനവും വിലയിരുത്തുക.)(10)
- Kidney Function Tests&eGFR (KFT): വൃക്കകളുടെ ആരോഗ്യവും ,വൃക്ക തകരാറുകൾ കണ്ടെത്തുകയും ചെയ്യുക(4)
- Calcium: (ഓസ്റ്റിയോപൊറോസിസ് പോലുള്ള അസ്ഥികളെ ബാധിക്കുന്ന അവസ്ഥകൾ വിലയിരുത്തുക)(1)
- Vitamin D (25-Hydroxy Vitamin D): (അസ്ഥികളെയും പ്രതിരോധശേഷിയെയും ബാധിക്കുന്ന കുറവ് കണ്ടെത്തുന്നു)(1)
- (നിർജ്ജലീകരണം, വൃക്കരോഗം പോലുള്ള അവസ്ഥകൾ നിരീക്ഷിക്കുക)(3)
- Lipid Profile (ഹൃദയ അപകടസാധ്യതയും ലിപിഡ് മെറ്റബോളിസവും വിലയിരുത്തുക)(7)
- TSH, Free T3 & Free T4 (തൈറോയ്ഡ് തകരാറുകൾ നിർണ്ണയിക്കുക)(3)
- Blood Pressure : (രക്തസമ്മർദ്ധം)(1)
Lab Technicians
Departments
Research Labs
Awards
Services
Opt for specimen collection in our cutting-edge laboratories or enjoy the ease of in-patient home/Office collection by simply requesting our dedicated home service in the most hygienic way
Walk-in patients are welcome during our opening hours without prior appointment, however. For patients younger than 4 years old we request you make an appointment to ensure that one of our technicians specially trained for collecting blood from young children is available.
Sample Collection
- Collection of biological samples at the lab premises for Special Tests and Semen Analysis
- Technical training and 'Real Time' support on sample handling and collection of biological samples
- Regular presentations and seminars
- Customized profiles according to clinic/doctor requirements
- Highly specialized tests/requests carried out in collaboration with major Special laboratories
- Collection personnel covering whole of Talipparamba and near by
- Collection personnel trained in maintenance of biological samples to make sure that they arrives in optimum conditions
- Appropriate containers and conditions provided to sample collectors to ensure appropriate delivery
Accurate and Reliable Results
We use state-of-the-art technology and equipment to ensure precision and reliability in every test.
All results are verified by experienced medical professionals.
Comprehensive Testing Services
From routine blood work to advanced diagnostic tests, we offer a wide range of services to meet all your healthcare needs.
Experienced Professionals
Our team includes skilled technicians with years of expertise in diagnostics.
Fast Turnaround Time
We understand the urgency of your health concerns and deliver accurate results quickly,
Home Sample Collection
Can't visit us? Our convenient home collection service ensures you get tested from the comfort of your home.
Affordable and Transparent Pricing
High-quality diagnostics at competitive prices with no hidden charges.
Cutting-Edge Technology
We continuously invest in the latest diagnostic equipment and methodologies for better accuracy and efficiency.
Patient-Centric Care
Your health is our priority. We provide personalized care and support to ensure a smooth experience.
Secure and Confidential
Your privacy matters to us. We maintain strict confidentiality for all test results and patient data.
Departments
Hematology
Hematology is the branch of medicine that focuses on the study, diagnosis, treatment, and prevention of diseases related to the blood and its components

Clinical Biochemistry
Clinical Biochemistry is the branch of laboratory medicine that focuses on analyzing bodily fluids, primarily blood and urine, to assess organ function and detect diseases. It plays a crucial role in diagnosing, monitoring, and managing a wide range of medical conditions.

Immunology & Endocrinology
Immunology & Endocrinology is the branch of biomedical science, studies immune system dysfunctions, such as allergies, autoimmune disorders, and immunodeficiencies.is the branch of medicine that studies hormones, their producing glands, and their effects on the body. It focuses on diagnosing and managing hormonal imbalances and endocrine disorders.

Clinical Pathology
Clinical Pathology is essential in diagnosing a wide range of diseases, including infections, cancers, metabolic disorders, and organ dysfunctions.

Gallery
Contact
Location
Allamkulam, Manna, Oppo: JJ Enterprises, Taliparamba, Pin 670141
Call Us
+91 85899 96091
Email Us
neethibiolabtpba@gmail.com